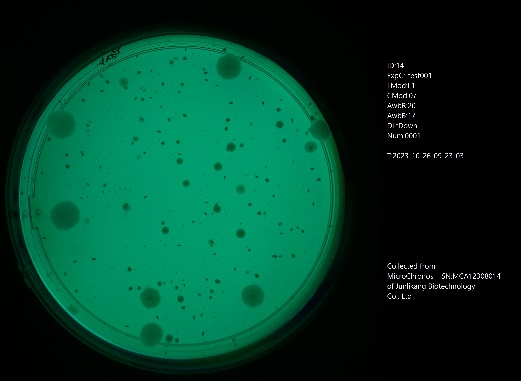
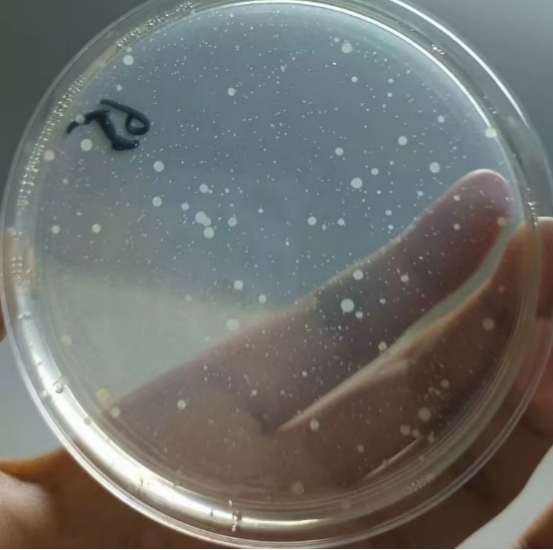

400-081-4789
400-081-4789首頁 / 產品中心 / 君立康MicroChronos 動態菌落計數系統
時間:2024-10-16 來源:admin 點擊:957次
君立康MicroChronos動態菌落計數系統采用高分辨率的工業相機、獨特的光源結構設計以及間隔拍攝設置,結合內置傳感器,還原最生動的微生物生長全過程圖像與實時環境及代謝信息。利用先進的深度學習檢測算法與圖像分割技術,對連續套圖進行精準計數,解決雜質難區分、黏連菌落難分割等計數難點,彌補終點觀察的缺陷。滿足醫院、大學科研院所、衛生防疫部門、疾病控制中心以及制藥、食品飲料、化妝品、培養基等行業的微生物檢測與研發需求。
1. 產品參數
|
儀器名稱 |
MicroChronos動態菌落計數系統 |
|
主要功能 |
菌落圖像采集(動態、靜態)、菌落計數 |
|
相機分辨率 |
1200萬像素 |
|
軟件 |
圖像采集軟件+菌落計數軟件 |
|
可識別最小菌落 |
0.05mm |
|
適用平皿規格 |
直徑90mm |
|
平皿類型 |
涂布、傾注 |
|
光源模式 |
上光源、下光源、紫外光源及組合光源 |
|
色彩還原 |
白平衡可調,亮度可調 |
|
傳感器參數 |
溫度、濕度、大氣壓強、CO2含量、VOC含量等 |
|
電源 |
內置可充電電池(2*8000mAh),電池續航72h |
|
尺寸及重量 |
123mm*123mm*185mm,0.96Kg |
|
工作方式 |
一臺電腦最多可連接16臺設備終端 |
|
安裝環境 |
64位,win10、win11系統 |
2.圖片采集亮點

創傷弧菌在CC平板上培養7.5h

創傷弧菌在CC平板上培養10h

創傷弧菌在CC平板上培養13.5h

創傷弧菌在CC平板上培養21h

上光源

下光源

紫外光源


原圖效果

調節白平衡參數,小菌落更易識別
3.計數亮點

微小菌落計數結果
微小菌落實際效果圖


動圖監測到的菌落融合

連續套圖的計數結果可進行菌落生長曲線的繪制

計數結果輔以人工復驗,數據可批量導出